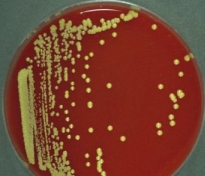
<p>Commensal, free-living GPC</p><p>Often arranged in regular packets of 4 or 8 <strong>(tetrads</strong>)</p><p><strong>CAT+ / COAG -</strong></p><p>Appear <strong><mark data-color="yellow" style="background-color: yellow; color: inherit;">yellow</mark></strong> and non-hemo on BAP</p><p>Generally contaminants</p>

1/31
Looks like no tags are added yet.
Name | Mastery | Learn | Test | Matching | Spaced | Call with Kai |
|---|
No analytics yet
Send a link to your students to track their progress

Staphylococcus

Micrococcus

Stomatococcus
GPC - grape-like clusters
Part of normal flora of skin & mucous membranes of humans/other warm blooded animals
Facultative anaerobes
Beta-hemo / CAT+ / DNAse+
Staphylococcus aureus
GPC - grape-like clusters
Part of normal flora of skin & mucous membranes of humans/other warm blooded animals
Facultative anaerobes
Non-hemo, white / CAT+ / DNAse+
Coagulase neg staphyloccoci
Catalase test differentiates:
Staph (+) from Strep (-)
Enzyme that breaks down hydrogen peroxide (H2O2) into H2O and O2
Catalase
False (+) risks of Catalase test (2)
1) Reverse order of steps, using an iron loop
2) Blood from BAP taken up with colony (RBCs contain small amount of catalase)
Coagulase test divides:
Coag ±Staph
Coag (+) - S. aureus
Coag (-) - S. epidermidis, S. saprophyticus, S. lugdunensis
What is the slide coag test?
Mix isolate with saline on slide
Add drop of plasma, mix, read immediately: clumps → positive
What is the free tube coag test?
Emulsify a loopful of isolate in small amount of plasma in a tube
Incubate 35C for 4 hours
Gently tilt tube: clot formation → positive
False positives for slide coag test
Organism autoagglutinates (clumps with saline)
Test not read within 10s (use BAP)
False negatives for tube coag test
S. aureus strains that lyse clot after prolonged incubation
Latex agglutination kit detects what?
Detect clumping factor and protein A
What can give false negative results in latex agglutination?
MRSA
What are the coag negative Staphs?
S. epidermidis
S. saprophyticus
S. lugdunensis
Most commonly isolated CNS?
S. epidermidis
What CNS is associated with UTIs (young women/older men) and Novobiocin resistant?
S. saprophyticus
What CNS is the frequent cause of endocarditis, ferments mannitol, PYR+, and frequently slide coag+?
S. lugdunensis
Colony: Opaque, smooth, beta-hemo
CAT+ / COAG+ / PYR -
Can tolerate high salt concentrations (MSA) → ferments mannitol (yellow colonies)
S. aureus
Most CNS do not ferment mannitol, so the colony colors will be:
Red/pink
S. aureus infections (7)
Skin
Gastrointestinal (via enterotoxin)
Pneumonia
Osteomyelitis
Endocarditis
Toxic Shock Syndrome
Scalded Skin Syndrome (caused by exofoliatin)
What infection is associated with toxin TSST-1 and high absorbency tampon use?
Toxic shock syndrome
What is the most important mechanism for MRSA resistance? What does it code for?
mecA gene - This gene codes for a new penicillin binding protein (PBP2a), with a low affinity for beta-lactam antimicrobics
What test can detect mecA gene?
PCRs
How does VRSA work?
Due to VanA operon that alters vancomycin’s cell wall target
Commensal, free-living GPC
Often arranged in regular packets of 4 or 8 (tetrads)
CAT+ / COAG -
Appear yellow and non-hemo on BAP
Generally contaminants
Micrococcus
What are the differential tests for Micrococcus?
Bacitracin and furazolidone susceptibility (lawn + disc method)
Modified oxidase test (detect cytochrome oxidase, blue = positive)
GPC in clumps or tetrads
CAT - (pseudocatalase) / Capsule +
“Stick Staph” bc it’s gray-white colonies strongly stick to agar
Part of normal flora
Rothia mucilaginosus
CAT +
Modified Oxidase -
Ferments glucose anaerobically +
Bacitracin R
Furazolidone S
Staphylococcus
CAT +
Modified Oxidase +
Ferments glucose anaerobically -
Bacitracin S
Furazolidone R
Micrococcus
CAT -
Modified Oxidase -
Ferments glucose anaerobically +
Bacitracin R
Furazolidone S
Stomatococcus